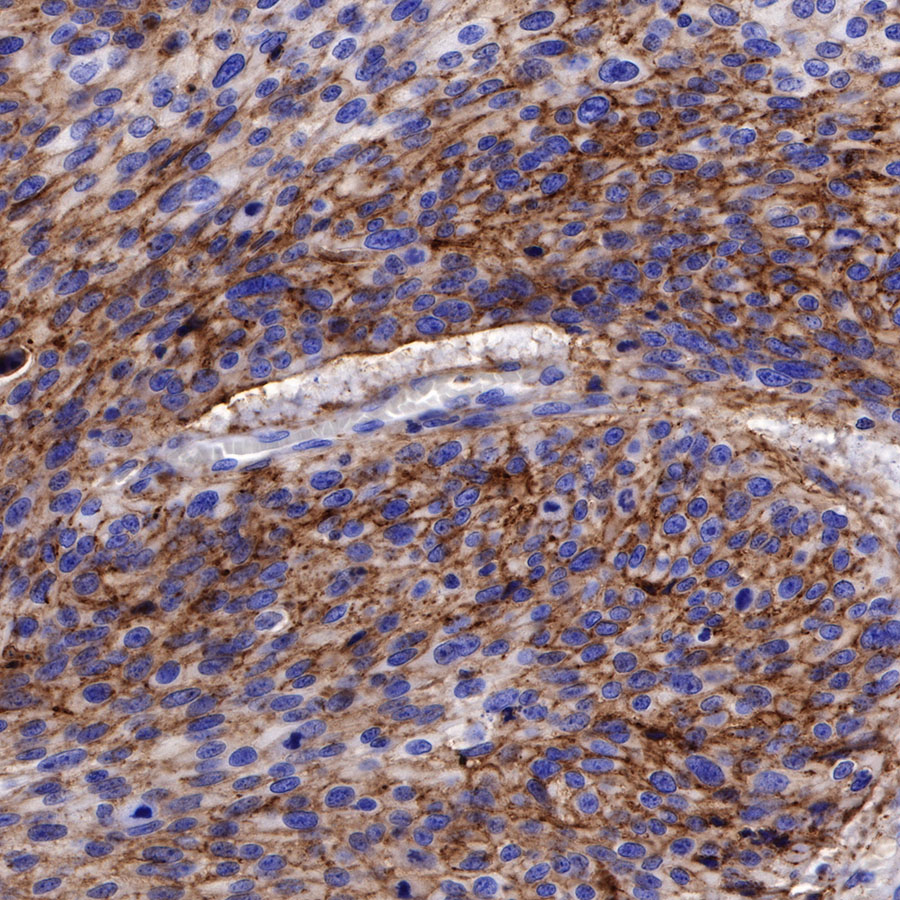
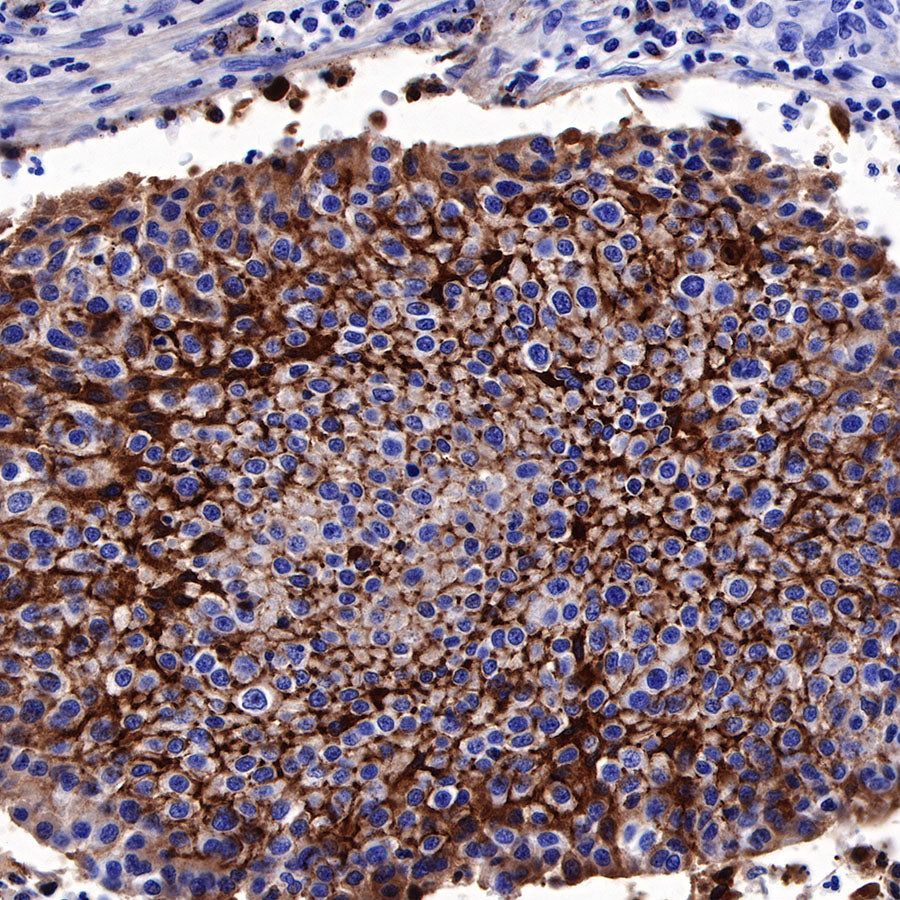

Product Details
Product Details
Product Specification
Host | Rabbit |
Antigen | CD138 |
Synonyms | Syndecan-1, SYND1, SDC1 |
Immunogen | N/A |
Location | Membrane |
Accession | P18827 |
Clone Number | SDT-R120 |
Antibody Type | Rabbit mAb |
Application | IHC-P, ICC |
Reactivity | Hu |
Purification | Protein A |
Concentration | 0.25 mg/ml |
Physical Appearance | Liquid |
Storage Buffer | PBS, 40% Glycerol, 0.05% BSA, 0.03% Proclin 300 |
Stability & Storage | 12 months from date of receipt / reconstitution, -20 °C as supplied |
Dilution
application | dilution | species |
IHC-P | 1:1000 | |
ICC | 1:25 |
Background
Syndecan-1 (CD138) is mostly restricted to epithelia, and bears heparan sulfate chains that are capable of interacting with a large array of polypeptides, including extracellular matrix components and potent mediators of proliferation, adhesion and migration. For this reason, it has been studied extensively with respect to carcinomas and tumor progression. Frequently, but not always, syndecan-1 levels decrease as tumor grade, stage and invasiveness and dedifferentiation increase. However, in some tumors, levels of syndecan-1 increase, but the characterization of its distribution is relevant. There can be loss of membrane staining, but acquisition of cytoplasmic and/or nuclear staining that is abnormal. Moreover, the appearance of syndecan-1 in the tumor stroma, either associated with its cellular component or the collagenous matrix, is nearly always a sign of poor prognosis [PMID: 33921767].
Picture
Picture
Immunohistochemistry

Immunocytochemistry

ICC shows positive staining in A431 cells. Anti-CD138 antibody was used at 1/25 dilution (Green) and incubated overnight at 4°C. Goat polyclonal Antibody to Rabbit IgG - H&L (Alexa Fluor® 488) was used as secondary antibody at 1/1000 dilution. The cells were fixed with 100% ice-cold methanol and permeabilized with 0.1% PBS-Triton X-100. Nuclei were counterstained with DAPI (Blue).

Negative control:ICC shows negative staining in Jurkat cells. Anti-CD138 antibody was used at 1/25 dilution and incubated overnight at 4°C. Goat polyclonal Antibody to Rabbit IgG - H&L (Alexa Fluor® 488) was used as secondary antibody at 1/1000 dilution. The cells were fixed with 100% ice-cold methanol and permeabilized with 0.1% PBS-Triton X-100. Nuclei were counterstained with DAPI (Blue).